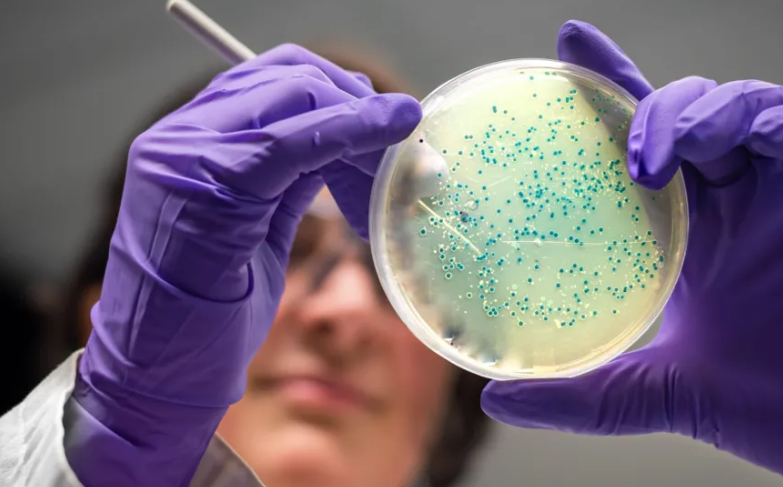

Antibiotikë “inteligjentë”/ Dy ilaçe të reja, sukses në testet laboratorike
Inteligjenca artificiale ka bërë një arritje mbresëlënëse, duke krijuar dy antibiotikë që mund të vrasin gonorrenë dhe stafilokokun rezistentë ndaj ilaçeve. Studiuesit nga Instituti I Teknologjisë në Masaçusets, thanë se ilaçet u projektuan atom pas atomi nga Inteligjenca artificiale dhe i vranë superbakteret në testet laboratorike dhe në kafshë. Të dyja përbërjet ende kanë nevojë [...]Read More...
Inteligjenca artificiale ka bërë një arritje mbresëlënëse, duke krijuar dy antibiotikë që mund të vrasin gonorrenë dhe stafilokokun rezistentë ndaj ilaçeve.
Studiuesit nga Instituti I Teknologjisë në Masaçusets, thanë se ilaçet u projektuan atom pas atomi nga Inteligjenca artificiale dhe i vranë superbakteret në testet laboratorike dhe në kafshë.
Të dyja përbërjet ende kanë nevojë për vite rafinimi dhe provash klinike përpara se të mund të jepet aprovimi për t’u përdorur te njerëëzit, por sipas studiuesve, kjo mund të fillojë epokën e dytë të artë të zbulimit të antibiotikëve.
Shkencëtarët e trajnuan inteligjencën artificiale duke I dhënë strukturën kimike të kompnimeve të njohura dhe të dhënat nëse ato ngadalësojnë rritjen e llojeve të ndryshme të baktereve.
Më pas inteligjenca artificiale mëson se si bakteret preken nga struktura të ndryshme molekulare, të ndërtuara nga atome si karboni, oksigjeni, hidrogjeni dhe azoti.
Pasi u prodhuan, modelet kryesore u testuan në baktere në laborator dhe në minj të infektuar, duke rezultuar në dy ilaçe të reja potenciale.
Megjithatë, ato nuk janë gati për prova klinike dhe ilaçet do të kërkojnë rafinim, që vlerësohet se do të zgjasë edhe një deri në dy vjet , përpara se të fillojë procesi i gjatë i testimit të tyre te njerëzit.
Antibiotikët vrasin bakteret, por infeksionet që i rezistojnë trajtimit tani po shkaktojnë më shumë se një milion vdekje në vit.
Përdorimi i tepërt i antibiotikëve ka ndihmuar bakteret të evoluojnë për të shmangur efektet e ilaçeve, dhe ka pasur mungesë të antibiotikëve të rinj për dekada të tëra.
Hulumtuesit kanë përdorur më parë inteligjencën artificiale për të shqyrtuar mijëra kimikate të njohura në një përpjekje për të identifikuar ato me potencial për t’u bërë antibiotikë të rinj./abcnews.al